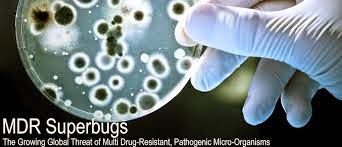

There are bugs (bacterial and
viral infectious organisms) at hospitals all over America and you can catch them by just getting routine tests or
medical work done. This is very scary. There are bugs in conventional meat and
dairy - big time! You can get very sick from drinking milk from CAFOs -
confined animal feeding operations. You can get very sick from eating fast food
meat, that's not taken care of properly during production (growth hormones and
antibiotics), during feeding (GMO corn and alfalfa), during processing (ammonia
and bleach) and during packaging and preserving (chemical additives and
preservatives).
Did you know your body is a
machine, and given the right whole foods daily and herbal supplements you will
have the best immune system possible in case of a needed "battle"
against Ebola, E-Coli, Salmonella, Superbugs, etc?!
It's true. You can build and
maintain your best immunity by NOT consuming chemicals in foods, drinks and
skin care products. Whatever you put on your skin your body
"consumes" so pay close attention there. Antibiotics and antibacterial
soaps and handwashes can weaken your
good bacteria, eliminating some or all of it at a given time, and that could be
the time your body encounters infection and needs to fight free radicals,
infectious disease or just plain bacteria and fungus. Most cancer is a fungus.
Look into superfoods and natural
medicine. Look into whole food, raw food and alkalizing your body. these are
the smart ways to be natural and organic and healthy, enjoying longevity
without the issues of preventable diseases and disorders so commonly seen in United States . You are worth it. Here's more from Natural Health News
online:
Per Natural News reports and
research:
" ... Finally, we have the
REAL war on bugs, and this is in regard to the kind that consume crops and the infectious
bacteria and viruses that are created by engineers for US biotech
"terror" in the form of mutated food and medicine, including inoculations.
Antibiotic "Overdose": Antibiotics are virtually useless in today's age, and they are often prescribed for viral infections, where they are beyond useless and actually damage the immune system, making the people MORE sick and vulnerable to infections and death. Plus, insects and blight are becoming more resistant to GMO pesticides and herbicides and are devastatingAmerica 's corn, oranges and more."
Learn more: http://www.naturalnews.com/047734_Big_Pharma_Biotech_engineered_disease.html#ixzz3K07TvgLD
Antibiotic "Overdose": Antibiotics are virtually useless in today's age, and they are often prescribed for viral infections, where they are beyond useless and actually damage the immune system, making the people MORE sick and vulnerable to infections and death. Plus, insects and blight are becoming more resistant to GMO pesticides and herbicides and are devastating
Learn more: http://www.naturalnews.com/047734_Big_Pharma_Biotech_engineered_disease.html#ixzz3K07TvgLD

Comments